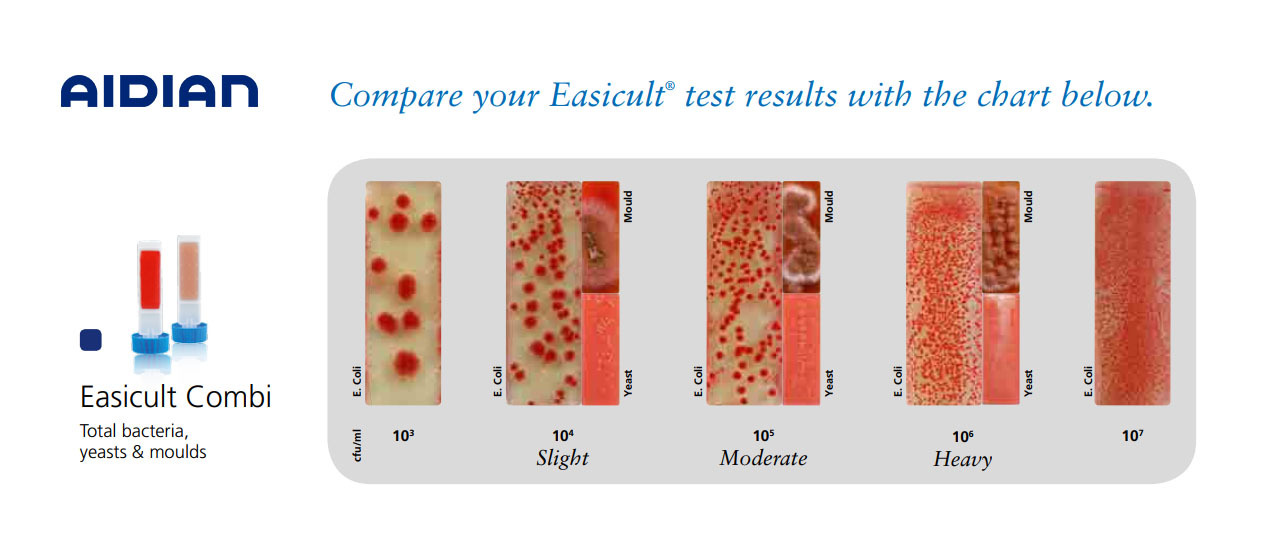

Easicult Combi菌落總數復合浸片 測菌片
細菌、酵母菌和霉菌很容易污染切削油、潤滑油、冷卻液、涂料和燃油,包括工業(yè)制造中的原材料,工藝用水,成品以及工序各個方面。在適宜的條件下,微生物會快速生長繁殖,引發(fā)嚴重的問題。Easicult系列工業(yè)液體檢測浸片可以廣泛應用于工業(yè)制造業(yè)中的微生物污染檢測和監(jiān)控,如金屬加工以及紙、涂料、燃油生產等。檢測工作可以預警微生物污染的狀況,為清潔和消毒程序提供判斷依據。
菌落總數和酵母菌&真菌檢測工業(yè)復合浸片 Easicult Combi (10片/盒)
Easicult Combi 設計應用于不同工業(yè)作業(yè)中的微生物污染檢測。浸片可以應用于現場直接檢測,也可以作為樣本的接種載體來使用。
浸片的一面澆注有TTC瓊脂(淡黃色),用于大多數普通細菌的培養(yǎng)。浸片的另一面澆注有玫瑰紅鈉瓊脂培養(yǎng)基(粉紅色),用于霉菌和酵母菌的培養(yǎng)。
1、為了避免污染,除了被檢測材料,浸片培養(yǎng)基不允許接觸任何其它材料。另一方面,浸片培養(yǎng)基與被測材料的充分接觸非常重要。
2、把浸片浸入到液體中,或者把液體噴在或涂抹在浸片上。浸片的兩面必須*濕潤,并與被檢測的液體接觸5—10秒鐘。

3、讓浸片上多余的液體流掉??梢栽诮锥朔胖靡粡埜蓛舻奈垼糜谖舳嘤嗟囊后w。

4、采樣完成后,把浸片放回培養(yǎng)管中并旋緊,在培養(yǎng)儀中或者直接放置在室溫下進行培養(yǎng)。

5、培養(yǎng)結果可以參照產品包裝盒中附帶的模板進行判讀。

Easicult Combi菌落總數復合浸片 測菌片